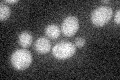
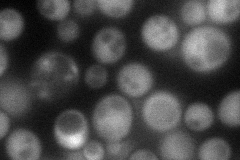
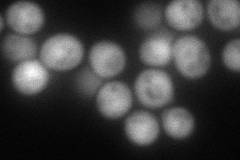

View description
RNA endoribonuclease involved in perinuclear mRNP quality control via the turnover of aberrant, unprocessed pre-mRNAs; interacts with subunits of THO/TREX, TREX-2, and RNA polymerase II; contains a PIN (PilT N terminus) domain
Localization:
Intensity:
Fold change:
Significance:
-
C’ GFP library in SD
below threshold18.5 -
N' NOP1pr-GFP in SD
cytosol82.7614 -
N' TEF2pr-mCherry in SD
cytosol116.487 -
N' NATIVEpr-GFP in SD

cytosol20.494 -
N' TEF2pr-VC and Cyto-VN in SD

#N/A0 -
C’ GFP library in SD+DTT

cytosol16.040.86No -
C’ GFP library in SD+H2O2

cytosol17.720.95No -
C’ GFP library in Starvation Media

cytosol13.450.72No -
C’ GFP library on the background of Pup2-DaMP

below threshold -
C’ GFP library on the background of CCT mutant

below threshold19.49031.05289No
